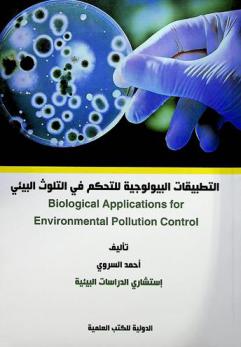
التطبيقات البيولوجية للتحكم في التلوث البيئي = Biological applications for environmental pollution control

Asset Details
MbrlCatalogueTitleDetail
Do you wish to reserve the book?

المعالجة الحيوية للملوثات البيئية : أساسيات ومبادئ
by
عبد الخالق، علاء الدين بيومي مؤلف
, القحطاني، علي بن سعيد محمد آل سرار مؤلف
, عوض الله، ياسر أبو بكر مؤلف
in
التكنولوجيا الحيوية جوانب بيئية
/ تلوث البيئة وقاية
2019

Hey, we have placed the reservation for you!
By the way, why not check out events that you can attend while you pick your title.
You are currently in the queue to collect this book. You will be notified once it is your turn to collect the book.

Oops! Something went wrong.
Looks like we were not able to place the reservation. Kindly try again later.
Are you sure you want to remove the book from the shelf?

Oops! Something went wrong.
While trying to remove the title from your shelf something went wrong :( Kindly try again later!
Do you wish to request the book?

المعالجة الحيوية للملوثات البيئية : أساسيات ومبادئ
by
عبد الخالق، علاء الدين بيومي مؤلف
, القحطاني، علي بن سعيد محمد آل سرار مؤلف
, عوض الله، ياسر أبو بكر مؤلف
in
التكنولوجيا الحيوية جوانب بيئية
/ تلوث البيئة وقاية
2019
Please be aware that the book you have requested cannot be checked out. If you would like to checkout this book, you can reserve another copy

We have requested the book for you!
Your request is successful and it will be processed during the Library working hours. Please check the status of your request in My Requests.

Oops! Something went wrong.
Looks like we were not able to place your request. Kindly try again later.

BOOK
المعالجة الحيوية للملوثات البيئية : أساسيات ومبادئ
2019
Available to read in the library!
Request Book From Autostore
and Choose the Collection Method
Overview
يعد هذا الكتاب من الكتب القليلة التي تناولت بشكل شامل المعالجة الحيوية للملوثات البيئية، ويوضح الكتاب الأساسيات والمبادئ التي تعتمد عليها التقنيات المتبعة في معالجة الملوثات البيئية بطرق حيوية نظراً لما تقدمه هذه الطرق من مميزات قد افتقدتها التقنيات التقليدية غير الحيوية خاصة في التربة والماء الأرضي، ويضم الكتاب ثلاثة عشر فصلا تتناول تاريخ وتعريف المعالجة الحيوية، ثم الحديث عن آليات تحول الملوثات وأساسيات الهدم الحيوي، ثم الانتقال إلى تقنيات المعالجة الحيوية باستخدام النباتات والفطريات لمعالجة الثلوث ببعض الملوثات المهمة مثل المبيدات والمعادن الثقيلة والمتفجرات والمنتجات البترولية والمركبات ثنائية الفينيل عديدة الكلوروفي الختام يتناول الكتاب بعض التقنيات النانوية لمعالجة الملوثات البيئية.
Publisher
دار جامعة الملك سعود للنشر
ISBN
9786035078047
Item info:
2
items available
2
items total in all locations
| Call Number | Copies | Material | Location |
|---|---|---|---|
| TD 192.5 .A23 2019 | 2 | BOOK | AUTOSTORE |
This website uses cookies to ensure you get the best experience on our website.